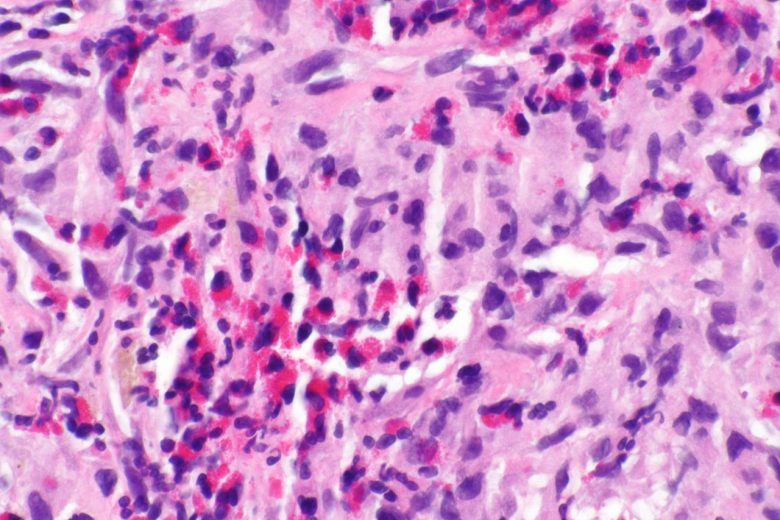

A cancer diagnosis can be both terrifying and confusing for those afflicted, as well as for friends and family who don’t really know what the diagnosis means.
It’s no wonder. There are so many types of cancer and so often the names of these diseases can sound scary. Knowing what these cancers are, the parts of the body they affect and how they are treated can help, and that’s the purpose of this article.
First, let’s start with the basics. Cancer is a collection of related diseases in which abnormal cells begin to divide. Left untreated, they can spread into other, nearby tissues, or can break free and travel to other parts of the body through the blood or lymph system. Different cancers can require different treatments, like chemotherapy, radiation therapy, or immunotherapy. Some cancers are more difficult to treat than others, particularly when they have metastasized or spread to other parts of the body.
For help with this project, we connected with the National Cancer Institute at the National Institutes of Health. The following list and descriptions are based on an index they developed detailing all of the various types of cancers.
Image Credit: Lance Liotta Laboratory / Wikimedia Commons.
Adrenocortical cancer

“Adrenocortical carcinoma is a rare disease in which malignant (cancer) cells form in the outer layer of the adrenal gland… Having certain genetic conditions increases the risk of adrenocortical carcinoma.
“Symptoms of adrenocortical carcinoma include pain in the abdomen… Imaging studies and tests that examine the blood and urine are used to detect (find) and diagnose adrenocortical carcinoma. Certain factors affect the prognosis (chance of recovery) and treatment options.”
Image Credit: Nephron / Wikimedia Commons.
Anal cancer

“Anal cancer cases have been increasing over several decades. Infection with human papillomavirus (HPV) is the major risk factor for anal cancer.
“Signs of anal cancer include bleeding from the anus or rectum or a lump near the anus. Tests that examine the rectum and anus are used to detect (find) and diagnose anal cancer. Certain factors affect the prognosis (chance of recovery) and treatment options.”
Image Credit: Cancer Research UK / WIkimedia Commons.
Brain cancer

“Brain and spinal cord (also known as central nervous system, or CNS) tumors can be benign or malignant.”
The different types of brain cancers include:
- Adult Central Nervous System Tumors Treatment
- Childhood Brain and Spinal Cord Tumors Treatment Overview
- Childhood Astrocytoma Treatment
- Childhood Atypical Teratoid/Rhabdoid Tumor Treatment
- Childhood Brain Stem Glioma Treatment
- Childhood Central Nervous System Embryonal Tumors Treatment
- Childhood Central Nervous System Germ Cell Tumors Treatment
- Childhood Craniopharyngioma Treatment
- Childhood Ependymoma Treatment
Image Credit: BruceBlaus / Wikimedia Commons.
Bile duct & liver cancer

“Liver cancer includes hepatocellular carcinoma (HCC) and bile duct cancer (cholangiocarcinoma). Risk factors for HCC include chronic infection with hepatitis B or C and cirrhosis of the liver.”
Find more information on the various forms of bile duct and liver cancers and their treatments here:
- Adult Primary Liver Cancer Treatment
- Bile Duct Cancer (Cholangiocarcinoma) Treatment
- Childhood Liver Cancer Treatment
Image Credit: Nephron / Wikimedia Commons.
Bladder cancer

“The most common type of bladder cancer is transitional cell carcinoma, also called urothelial carcinoma. Smoking is a major risk factor for bladder cancer. Bladder cancer is often diagnosed at an early stage. For more information, view bladder cancer symptoms, tests, prognosis, and stages.”
Image Credit: Cancer Research UK / Wikimedia Commons.
Bone cancer

“Bone cancer is rare and includes several types. Some bone cancers, including osteosarcoma and Ewing sarcoma, are seen most often in children and young adults.”
For more information, see:
The NIH’s primary bone cancer fact sheet has additional basic information.
Image Credit: National Cancer Institute / Wikimedia Commons.
Breast cancer

“Breast cancer is the second most common cancer in women after skin cancer. Mammograms can detect breast cancer early, possibly before it has spread.”
For more information on treatments:
Image Credit: National Cancer Institute / Wikimedia Commons.
Carcinoid tumors

“Gastrointestinal (GI) carcinoid tumors are slow-growing tumors that form in the GI tract, mainly in the rectum, small intestine, or appendix.”
Learn more about treatments here.
Image Credit: Yale Rosen / Wikimedia Commons.
Carcinoma of unknown primary

“Cancer of unknown primary (CUP) occurs when cancer cells have spread in the body and formed metastatic tumors but the site of the primary cancer is not known.
“Sometimes the primary cancer is never found. The signs and symptoms of CUP are different, depending on where the cancer has spread in the body.”
Additional information:
- Different tests are used to detect cancer.
- If tests show there may be cancer, a biopsy is done.
- When the type of cancer cells or tissue removed is different from the type of cancer cells expected to be found, a diagnosis of CUP may be made.
- Tests and procedures used to find the primary cancer depend on where the cancer has spread.
- Certain factors affect prognosis.
Image Credit: Ed Uthman / Wikimedia Commons.
Cervical cancer

“Cervical cancer is nearly always caused by infection with human papillomavirus (HPV).
“There are usually no signs or symptoms of early cervical cancer but it can be detected early with regular check-ups. Signs and symptoms of cervical cancer include vaginal bleeding and pelvic pain.
“Tests that examine the cervix are used to detect (find) and diagnose cervical cancer. Certain factors affect prognosis (chance of recovery) and treatment options.”
Image Credit: National Cancer Institute / Wikimedia Commons.
Childhood cancers

“In the United States in 2019, an estimated 11,060 new cases of cancer will be diagnosed among children from birth to 14 years, and about 1,190 children are expected to die from the disease. Although cancer death rates for this age group have declined by 65 percent from 1970 to 2016, cancer remains the leading cause of death from disease among children. The most common types of cancer diagnosed in children ages 0 to 14 years are leukemias, brain and other central nervous system (CNS) tumors, and lymphomas.”
Rare or unusual childhood cancers include:
- Multiple endocrine neoplasia syndromes
- Pheochromocytoma and paraganglioma
- Skin cancer (melanoma, squamous cell cancer, basal cell cancer)
- Intraocular (uveal) melanoma
- Chordoma
- Cancer of unknown primary site
- Childhood midline tract carcinoma
Image Credit: Nephron / Wikimedia Commons.
Chronic myeloproliferative neoplasms

“Myeloproliferative neoplasms and myelodysplastic syndromes are diseases of the blood cells and bone marrow. Sometimes both conditions are present.”
Learn more about the types of myeloproliferative neoplasms here:
- Myelodysplastic syndromes
- Chronic myeloproliferative neoplasms
- Myelodysplastic/ myeloproliferative neoplasms
Image Credit: TomskiiJA / Wikimedia Commons.
Colorectal cancer

“Colorectal cancer often begins as a growth called a polyp inside the colon or rectum. Finding and removing polyps can prevent colorectal cancer.”
Learn more about treatments here:
Image Credit: Patho / Wikimedia Commons.
Esophageal cancer

“The most common types of esophageal cancer are adenocarcinoma and squamous cell carcinoma. These two forms of esophageal cancer tend to develop in different parts of the esophagus and are driven by different genetic changes.
“Smoking, heavy alcohol use, and Barrett esophagus can increase the risk of esophageal cancer. Signs and symptoms of esophageal cancer are weight loss and painful or difficult swallowing. Tests that examine the esophagus are used to detect (find) and diagnose esophageal cancer.”
Image Credit: Nephron / Wikimedia Commons.
Extragonadal germ cell tumors

“Extragonadal germ cell tumors develop from germ cells (fetal cells that give rise to sperm and eggs). Extragonadal germ cell tumors form outside the gonads (testicles and ovaries).”
“Age and gender can affect the risk of extragonadal germ cell tumors. Signs and symptoms of extragonadal germ cell tumors include breathing problems and chest pain.
Imaging and blood tests are used to detect (find) and diagnose extragonadal germ cell tumors.”
Image Credit: Libertas Academica / Wikimedia Commons.
Eye cancer

“There are two primary types of eye cancer, intraocular melanoma and retinoblastoma.”
“Intraocular melanoma is a rare cancer … [that] usually has no early signs or symptoms. As with melanoma of the skin, risk factors include having fair skin and light-colored eyes.“Retinoblastoma is a very rare childhood cancer that forms in the tissues of the retina. It can occur in one or both eyes. Most cases of retinoblastoma are not inherited, but some are, and children with a family history of the disease should have their eyes checked beginning at an early age.”
Image Credit: US Air Force Medical Service.
Fallopian tube cancer

“Ovarian epithelial cancer, fallopian tube cancer, and primary peritoneal cancer form in the same kind of tissue and are treated in the same way. These cancers are often advanced at diagnosis. Less common types of ovarian tumors include ovarian germ cell tumors and ovarian low malignant potential tumors.”
Learn more:
- Ovarian epithelial, fallopian, & peritoneal cancer
- Ovarian germ cell tumors
- Ovarian low malignant potential tumors
Image Credit: Ed Uthman / Flickr.
Gallbladder cancer

“Gallbladder cancer is a rare cancer that is usually diagnosed late due a to lack of early signs and symptoms. It is sometimes found when the gallbladder is checked for gallstones or removed.”
There are three types of standard treatment used:
- Surgery
- Radiation therapy
- Chemotherapy
New types of treatment are being tested in clinical trials, including radiation sensitizers.
Image Credit: Wikimedia Commons.
Gastric (stomach) cancer

“Gastric (stomach) cancer occurs when cancer cells form in the lining of the stomach. Risk factors include smoking, infection with H. pylori bacteria, and certain inherited conditions.
“Age, diet and stomach disease can affect the risk of developing gastric cancer. Symptoms of gastric cancer include indigestion and stomach discomfort or pain.
“Tests that examine the stomach and esophagus are used to detect (find) and diagnose gastric cancer.”
Image Credit: Nephron / Wikimedia Commons.
Gastrointestinal carcinoid tumors

“Gastrointestinal (GI) carcinoid tumors are slow-growing tumors that form in the GI tract, mainly in the rectum, small intestine, or appendix.”
- Health history can affect the risk of gastrointestinal carcinoid tumors.
- Some gastrointestinal carcinoid tumors have no signs or symptoms in the early stages.
- Carcinoid syndrome may occur if the tumor spreads to the liver or other parts of the body.
- Imaging studies and tests that examine the blood and urine are used to detect (find) and diagnose gastrointestinal carcinoid tumors.
Image Credit: KGH / Wikimedia Commons.
Gestational trophoblastic disease

“In gestational trophoblastic disease (GTD), a tumor develops inside the uterus from tissue that forms after conception (the joining of sperm and egg). This tissue is made of trophoblast cells and normally surrounds the fertilized egg in the uterus. Trophoblast cells help connect the fertilized egg to the wall of the uterus and form part of the placenta (the organ that passes nutrients from the mother to the fetus).
“Sometimes there is a problem with the fertilized egg and trophoblast cells. Instead of a healthy fetus developing, a tumor forms. Until there are signs or symptoms of the tumor, the pregnancy will seem like a normal pregnancy.”
More facts about GTD:
- Hydatidiform mole (HM) is the most common type of GTD.
- Gestational trophoblastic neoplasia (GTN) is a type of gestational trophoblastic disease (GTD) that is almost always malignant.
- Age and a previous molar pregnancy affect the risk of GTD.
- Signs of GTD include abnormal vaginal bleeding and a uterus that is larger than normal.
- Tests that examine the uterus are used to detect (find) and diagnose gestational trophoblastic disease.
Image Credit: Nephron / Wikimedia Commons.
Head & neck cancers

“Head and neck cancers include cancers in the larynx, throat, lips, mouth, nose, and salivary glands. Tobacco use, heavy alcohol use, and infection with human papillomavirus (HPV) increase the risk of head and neck cancers.”
These cancers include:
- Hypopharyngeal cancer
- Laryngeal cancer
- Lip and oral cavity cancer
- Metastatic squamous neck cancer with occult primary
- Nasopharyngeal cancer
- Oropharyngeal cancer
- Paranasal sinus and nasal cavity cancer
- Salivary gland cancer
Image Credit: KGH / Wikimedia Commons.
Langerhans cell histiocytosis
“Langerhans cell histiocytosis (LCH) is a rare cancer that begins in LCH cells. LCH cells are a type of dendritic cell which fights infection. Sometimes there are mutations (changes) in LCH cells as they form. These include mutations of the BRAF , MAP2K1, RAS and ARAF genes. These changes may make the LCH cells grow and multiply quickly. This causes LCH cells to build up in certain parts of the body, where they can damage tissue or form lesions.
“Family history of cancer or having a parent who was exposed to certain chemicals may increase the risk of LCH.”
The signs and symptoms of LCH depend on where it is in the body:
- Skin and nails
- Mouth
- Bone
- Lymph nodes and thymus
- Endocrine system
- Eye
- Central nervous system (CNS)
- Liver and spleen
- Lung
- Bone marrow
Image Credit: Librepath / Wikimedia Commons.
Kidney cancer

“Kidney cancer can develop in adults and children. The main types of kidney cancer are renal cell cancer, transitional cell cancer, and Wilms tumor. Certain inherited conditions increase the risk of kidney cancer.”
Lear more about the types of kidney cancers:
- Renal Cell cancer
- Transitional Cell cancer (kidney/ureter)
- Wilms tumor and other childhood kidney tumors
Image Credit: Nephron / Wikimedia Commons.
Leukemia

“Leukemia is a broad term for cancers of the blood cells… The type of leukemia depends on the type of blood cell that becomes cancer and whether it grows quickly or slowly.
“Leukemia occurs most often in adults older than 55, but it is also the most common cancer in children younger than 15.”
There are various types of leukemia, including:
- Adult acute lymphoblastic
- Adult acute myeloid leukemia
- Chronic lymphocytic leukemia
- Chronic myelogenous leukemia
- Hairy cell leukemia
- Childhood acute lymphoblastic leukemia
- Childhood acute myeloid leukemia
Image Credit: National Cancer Institute / Wikimedia Commons.
Lung cancer

“Lung cancer includes two main types: non-small cell lung cancer and small cell lung cancer. Smoking causes most lung cancers, but nonsmokers can also develop lung cancer.”
Learn more about the types of lung cancer:
Image Credit: Yale Rosen / Wikimedia Commons.
Lymphoma

“Lymphoma is a broad term for cancer that begins in cells of the lymph system. The two main types are Hodgkin lymphoma and non-Hodgkin lymphoma (NHL). Hodgkin lymphoma can often be cured. The prognosis of NHL depends on the specific type.”
Learn more about the different types of lymphoma:
- Adult Hodgkin lymphoma
- Adult non-Hodgkin lymphoma
- AIDS-related lymphoma
- Mycosis fungoides (including Sézary syndrome)
- Primary CNS lymphoma
- Childhood Hodgkin lymphoma
- Childhood non-Hodgkin lymphoma
Image Credit: Nephron / Wikimedia Commons.
Malignant mesothelioma

“Malignant mesothelioma is a cancer of the thin tissue (mesothelium) that lines the lung, chest wall, and abdomen. The major risk factor for mesothelioma is asbestos exposure.
“Different types of treatments are available for patients with malignant mesothelioma. Some treatments are standard (the currently used treatment), and some are being tested in clinical trials. A treatment clinical trial is a research study meant to help improve current treatments or obtain information on new treatments for patients with cancer.”
Image Credit: Nephron / Wikimedia Commons.
Metastatic cancer

“The main reason that cancer is so serious is its ability to spread in the body. Cancer cells can spread locally by moving into nearby normal tissue. Cancer can also spread regionally, to nearby lymph nodes, tissues, or organs. And it can spread to distant parts of the body. When this happens, it is called metastatic cancer. For many types of cancer, it is also called stage IV (four) cancer. The process by which cancer cells spread to other parts of the body is called metastasis.
“When observed under a microscope and tested in other ways, metastatic cancer cells have features like that of the primary cancer and not like the cells in the place where the cancer is found. This is how doctors can tell that it is cancer that has spread from another part of the body.
“Metastatic cancer has the same name as the primary cancer. For example, breast cancer that spreads to the lung is called metastatic breast cancer, not lung cancer. It is treated as stage IV breast cancer, not as lung cancer.”
Image Credit: Ed Uthman / WIkimedia Commons.
Multiple myeloma & plasma cell neoplasms

“Plasma cell neoplasms occur when abnormal plasma cells form cancerous tumors in bone or soft tissue. When there is only one tumor, the disease is called a plasmacytoma. When there are multiple tumors, it is called multiple myeloma.
“Plasma cell neoplasms are diseases in which the body makes too many plasma cells.
“Plasma cells develop from B lymphocytes (B cells), a type of white blood cell that is made in the bone marrow. Normally, when bacteria or viruses enter the body, some of the B cellswill change into plasma cells. The plasma cells make antibodies to fight bacteria and viruses, to stop infection and disease.”
Image Credit: Dr Erhabor Osaro / Wikimedia Commons.
Myeloproliferative neoplasms & myelodysplastic syndromes

“Myeloproliferative neoplasms and myelodysplastic syndromes are diseases of the blood cells and bone marrow. Sometimes both conditions are present.
“Normally, the bone marrow makes blood stem cells (immature cells) that become mature blood cells over time.”
“In myelodysplastic diseases, the blood stem cells do not mature into healthy red blood cells, white blood cells, or platelets. The immature blood cells, called blasts, do not work the way they should and die in the bone marrow or soon after they enter the blood. As a result, there are fewer healthy red blood cells, white blood cells, and platelets.
“In myeloproliferative diseases, a greater than normal number of blood stem cells become one or more types of blood cells and the total number of blood cells slowly increases.”
Learn more about:
- Myelodysplastic syndromes treatment
- Chronic myeloproliferative neoplasms treatment
- Myelodysplastic/ myeloproliferative neoplasms treatment
Image Credit: TomskiiJA / Wikimedia Commons.
Neuroblastoma

“Neuroblastoma is a cancer of immature nerve cells that most often occurs in young children. It usually begins in the adrenal glands but can form in the neck, chest, abdomen, and spine.
“Neuroblastoma most often begins in infancy and may be diagnosed in the first month of life. It is found when the tumor begins to grow and cause signs or symptoms. Sometimes it forms before birth and is found during a fetal ultrasound.
“By the time neuroblastoma is diagnosed, the cancer has usually metastasized (spread). Neuroblastoma spreads most often to the lymph nodes, bones, bone marrow, and liver. In infants, it also spreads to the skin.”
Other facts to know about neuroblastoma:
- Neuroblastoma is sometimes caused by a gene mutation (change) passed from the parent to the child.
- Signs and symptoms of neuroblastoma include bone pain and a lump in the abdomen, neck, or chest.
- Tests that examine many different body tissues and fluids are used to detect (find) and diagnose neuroblastoma.
- A biopsy is done to diagnose neuroblastoma.
Image Credit: Sarahkayb / Wikimedia Commons.
Ovarian, fallopian tube, and primary peritoneal cancer

“Ovarian epithelial cancer, fallopian tube cancer, and primary peritoneal cancer form in the same kind of tissue and are treated in the same way. These cancers are often advanced at diagnosis. Less common types of ovarian tumors include ovarian germ cell tumors and ovarian low malignant potential tumors.”
Learn more about the different treatments available for patients:
- Treatment of ovarian epithelial, fallopian, & peritoneal Cancer
- Treatment of ovarian germ cell tumors
- Treatment of ovarian low malignant potential tumors
Image Credit: Nephron / Wikimedia Commons.
Pancreatic cancer

“Pancreatic cancer can develop from two kinds of cells in the pancreas: exocrine cells and neuroendocrine cells, such as islet cells. The exocrine type is more common and is usually found at an advanced stage. Pancreatic neuroendocrine tumors (islet cell tumors) are less common but have a better prognosis.”
Important facts about pancreatic cancer:
Image Credit: Nephron / Wikimedia Commons.
Parathyroid cancer

“Parathyroid tumors are usually benign (not cancer) and are called adenomas. Parathyroid cancer is very rare. Having certain inherited disorders can increase the risk of parathyroid cancer.”
Important facts about parathyroid cancer:
- Having certain inherited disorders can increase the risk of developing parathyroid cancer.
- Signs and symptoms of parathyroid cancer include weakness, feeling tired, and a lump in the neck.
- Tests that examine the neck and blood are used to detect (find) and diagnose parathyroid cancer.
Image Credit: Nephron / Wikimedia Commons.
Penile cancer

“Penile cancer usually forms on or under the foreskin. Human papillomavirus (HPV) causes about one-third of penile cancer cases. When found early, penile cancer is usually curable.
“Signs of penile cancer include sores, discharge, and bleeding. Tests that examine the penis are used to detect (find) and diagnose penile cancer.”
Image Credit: Nephron / Wikimedia Commons.
Pituitary tumors

“Pituitary tumors are usually not cancer and are called pituitary adenomas. They grow slowly and do not spread. Rarely, pituitary tumors are cancer and they can spread to distant parts of the body.
“Different types of treatments are available for patients with pituitary tumors. Some treatments are standard (the currently used treatment), and some are being tested in clinical trials.”
In general, four types of standard treatment are used:
- Surgery
- Radiation therapy
- Drug therapy
- Chemotherapy
Image Credit: Jensflorian / Wikimedia Commons.
Prostate cancer

“Prostate cancer is the most common cancer and the second leading cause of cancer death among men in the United States. Prostate cancer usually grows very slowly, and finding and treating it before symptoms occur may not improve men’s health or help them live longer.”
Check with your doctor if you have any of the following:
- Weak or interrupted (“stop-and-go”) flow of urine.
- Sudden urge to urinate.
- Frequent urination (especially at night).
- Trouble starting the flow of urine.
- Trouble emptying the bladder completely.
- Pain or burning while urinating.
- Blood in the urine or semen.
- A pain in the back, hips, or pelvis that doesn’t go away.
- Shortness of breath, feeling very tired, fast heartbeat, dizziness, or pale skin caused by anemia.
Image Credit: Nephron / Wikimedia Commons.
Recurrent cancer

“When cancer comes back after treatment, doctors call it a recurrence or recurrent cancer. Finding out that cancer has come back can cause feelings of shock, anger, sadness, and fear. But you have something now that you didn’t have before—experience.
“You’ve lived through cancer already and you know what to expect. Also, remember that treatments may have improved since you were first diagnosed. New drugs or methods may help with your treatment or in managing side effects. In some cases, improved treatments have helped turn cancer into a chronic disease that people can manage for many years.”
Image Credit: Jensflorian / Wikimedia Commons.
Sarcoma

“The term ‘sarcoma’ encompasses a broad family of rare cancers that can affect soft tissue or bone throughout the body, and sometimes both.”
There are many different types of sarcomas. Learn more about each at the following links:
- Childhood rhabdomyosarcoma (soft tissue sarcoma)
- Childhood vascular tumors (soft tissue sarcoma)
- Ewing sarcoma (bone cancer)
- Kaposi sarcoma (soft tissue sarcoma)
- Osteosarcoma (bone cancer)
- Soft tissue sarcoma
- Uterine sarcoma
Image Credit: Jerad M Gardner, MD / Wikimedia Commons.
Skin cancer

“Skin cancer is the most common type of cancer. The main types of skin cancer are squamous cell carcinoma, basal cell carcinoma, and melanoma. Melanoma is much less common than the other types but much more likely to invade nearby tissue and spread to other parts of the body. Most deaths from skin cancer are caused by melanoma.”
Learn more about the different types of skin cancers in the following links:
Image Credit: Mateus Figueiredo / Wikimedia Commons.
Small intestine cancer

“Small intestine cancer usually begins in an area of the intestine called the duodenum. This cancer is rarer than cancers in other parts of the gastrointestinal system, such as the colon and stomach.
“The types of cancer found in the small intestine are adenocarcinoma, sarcoma, carcinoid tumors, gastrointestinal stromal tumor, and lymphoma.
“Diet and health history can affect the risk of developing small intestine cancer. Signs and symptoms of small intestine cancer include unexplained weight loss and abdominal pain. Tests that examine the small intestine are used to detect (find), diagnose, and stage small intestine cancer.”
Image Credit: Nephron / Wikimedia Commons.
Testicular cancer

“Testicular cancer most often begins in germ cells (cells that make sperm). It is rare and is most frequently diagnosed in men 20-34 years old. Most testicular cancers can be cured, even if diagnosed at an advanced stage.”
Risk factors for testicular cancer include:
- Having had an undescended testicle.
- Having had abnormal development of the testicles.
- Having a personal history of testicular cancer.
- Having a family history of testicular cancer (especially in a father or brother).
- Being white.
Image Credit: Nephron / Wikimedia Commons.
Thymoma and thymic carcinoma

“Thymomas and thymic carcinomas are rare tumors that form in cells on the thymus [a gland behind the breastbone that produces T-cells, a type of white blood cells].
“Thymomas grow slowly and rarely spread beyond the thymus. Thymic carcinoma grows faster, often spreads to other parts of the body, and is harder to treat.”
You can learn more here.
Image Credit: Humpath / Wikimedia Commons.
Thyroid cancer

“Thyroid cancer is a disease in which malignant (cancer) cells form in the tissues of the thyroid gland.
“Thyroid cancer can be of four main types, which vary in their aggressiveness. Anaplastic thyroid cancer is hard to cure with current treatments, whereas papillary (the most common), follicular, and medullary thyroid cancer can usually be cured.”
You can learn more about causes, symptoms and treatments here.
Image Credit: Yale Rosen / Wikimedia Commons.
Urethral cancer

“The urethra is the tube that carries urine from the bladder to outside the body… Urethral cancer is rare, but is more common in men than in women. Urethral cancer can metastasize (spread) quickly to tissues around the urethra and has often spread to nearby lymph nodes by the time it is diagnosed.”
Risk factors for urethral cancer include the following:
- Having a history of bladder cancer.
- Having conditions that cause chronic inflammation in the urethra, including:
- Sexually transmitted diseases (STDs), including human papillomavirus (HPV), especially HPV type 16.
- Frequent urinary tract infections (UTIs).
Image Credit: Nephron / Wikimedia Commons.
Uterine cancer

“Uterine cancers can be of two types: endometrial cancer (common) and uterine sarcoma (rare). Endometrial cancer can often be cured. Uterine sarcoma is often more aggressive and harder to treat.
“Endometrial cancer is a disease in which malignant (cancer) cells form in the tissues of the endometrium. Obesity and having metabolic syndrome may increase the risk of endometrial cancer.
“Taking tamoxifen for breast cancer or taking estrogen alone (without progesterone) can increase the risk of endometrial cancer. Signs and symptoms of endometrial cancer include unusual vaginal bleeding or pain in the pelvis.
“Uterine sarcoma is a disease in which malignant (cancer) cells form in the muscles of the uterus or other tissues that support the uterus. Past treatment with radiation therapy to the pelvis can increase the risk of uterine sarcoma. Signs of uterine sarcoma include abnormal bleeding.”Image Credit: Nephron / Wikimedia Commons.
Vaginal cancer

“Infection with human papillomavirus (HPV) causes two-thirds of the cases of vaginal cancer. Vaccines that protect against infection with HPV may reduce the risk of vaginal cancer. When found early, vaginal cancer can often be cured.”
Risk factors for vaginal cancer include the following:
- Being aged 60 or older.
- Being exposed to DES while in the mother’s womb. In the 1950s, the drug DES was given to some pregnant women to prevent miscarriage (premature birth of a fetus that cannot survive). Women who were exposed to DES before birth have an increased risk of vaginal cancer. Some of these women develop a rare form of vaginal cancer called clear cell adenocarcinoma.
- Having human papilloma virus (HPV) infection.
- Having a history of abnormal cells in the cervix or cervical cancer.
- Having a history of abnormal cells in the uterus or cancer of the uterus.
- Having had a hysterectomy for health problems that affect the uterus.
Image Credit: National Cancer Institute / Wikimedia Commons.
Vulvar cancer

“Vulvar cancer usually forms slowly over years, most often on the vaginal lips or the sides of the vaginal opening. Infection with human papillomavirus (HPV) causes about half of all vulvar cancers.”
Risk factors for vulvar cancer include the following:
- Having vulvar intraepithelial neoplasia (VIN).
- Having human papillomavirus (HPV) infection.
- Having a history of genital warts.
Other possible risk factors include the following:
- Having many sexual partners.
- Having first sexual intercourse at a young age.
- Having a history of abnormal Pap tests (Pap smears).
Image Credit: Nephron / Wikimedia Commons.





